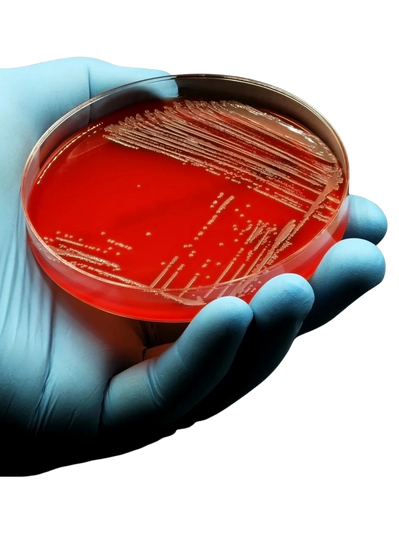

Antimicrobial resistance (AMR) jeopardizes modern medicine, food security, and environmental health. These resistant pathogens are spreading at an exponential rate and require a continued coordinated effort across One Health domains. Limited resources and an imbalance of perspectives further threaten progress made to date.
The AMR Strategic Coalition (ASC) is an independent organization that leads cross-sector coordination to establish a unified stance on US-based policy positions on AMR. We convene public health, scientific, veterinary, industry, and advocacy organizations to build consensus on strategic priorities and amplify impact across the One Health spectrum. By ensuring balance in perspectives and establishing shared priorities, our aim is to develop policy postures that are truly synergistic and reflective of the US-based community.
We are trusted independent leaders with over a decade of deep federal policy, facilitation, and scientific experience coordinating AMR efforts. Experts in leading coalitions and ensuring balance in representation and input to deliver sustained impact in the fight against AMR.

Amplify stakeholder voices though sustained collaboration to safeguard hard-won gains and influence future U.S. and global AMR efforts

Support the U.S. government with open and transparent discussions and provide
policy solutions developed by stakeholders in human and agricultural sciences

Coordinate discussions that generate consensus-based policy and actionable
priorities across sectors

If you are interested in supporting ASC and our important work please contact us!
Copyright © 2025 AMR Strategic Coalition - All Rights Reserved.